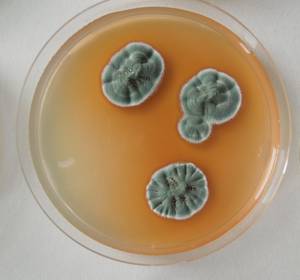
MSU_FS-02660 01, Район Кон Плонг (Kon Plông district), Провинция Контум (Kon Tum province) (Вьетнам)
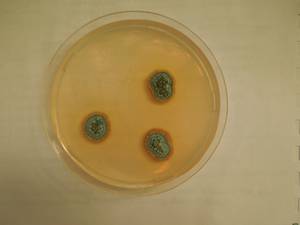
MSU_FS-01222 01, Район Бао Лам (Bảo Lâm district), Провинция Ламдонг (Lâm Đồng province) (Вьетнам)

Всего записей: 2
Всего страниц: 1
По организмам
- ID образца
- 0000000905764
- Вид
- Penicillium coprophilum
- Штамм
- MSU_FS-02660
- Место сбора
- Район Кон Плонг (Kon Plông district), Провинция Контум (Kon Tum province) (Вьетнам)
- Топоним
- Манг Кань (Măng Cành commune)
- ID образца
- 0000000903932
- Вид
- Penicillium coprophilum
- Штамм
- MSU_FS-01222
- Место сбора
- Район Бао Лам (Bảo Lâm district), Провинция Ламдонг (Lâm Đồng province) (Вьетнам)
- Топоним
- Лок Бао (Lộc Bảo)